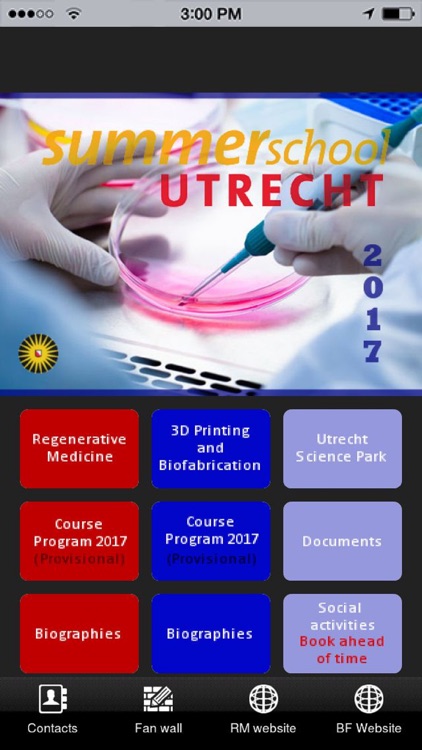
Summer School Utrecht M18 - M4

You are using an outdated browser. Please
upgrade your browser to improve your experience.

Official Utrecht Summer School App for the courses: Regenerative Medicine (M18) and 3D Printing & Biofabrication (M4)

Summer School Utrecht M18 - M4
by Bart Spee



What is it about?
Official Utrecht Summer School App for the courses: Regenerative Medicine (M18) and 3D Printing & Biofabrication (M4).

App Screenshots

App Store Description
Official Utrecht Summer School App for the courses: Regenerative Medicine (M18) and 3D Printing & Biofabrication (M4).
Disclaimer:
AppAdvice does not own this application and only provides images and links contained in the iTunes Search API, to help our users find the best apps to download. If you are the developer of this app and would like your information removed, please send a request to takedown@appadvice.com and your information will be removed.
AppAdvice does not own this application and only provides images and links contained in the iTunes Search API, to help our users find the best apps to download. If you are the developer of this app and would like your information removed, please send a request to takedown@appadvice.com and your information will be removed.